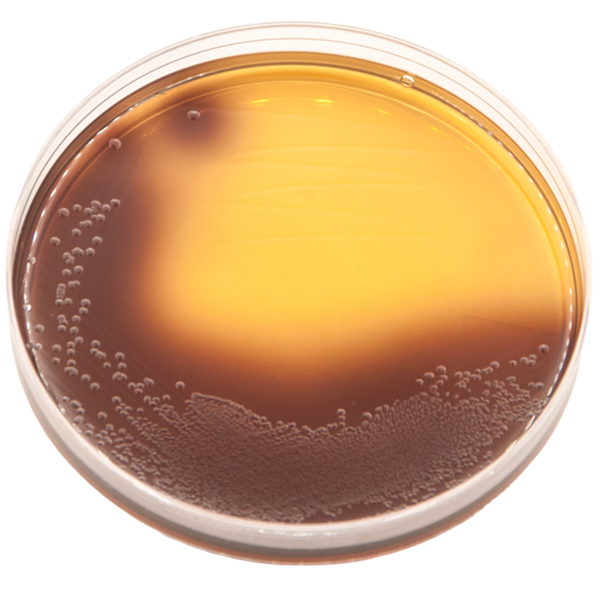

Anaerobe Systems Media
Anaerobic organisms play critical roles in health and disease pathology of humans and animals, as well as throughout the Earth’s ecosystems. Isolating and culturing these fastidious organisms with consistent results requires specialized conditions.
Your research can benefit from our decades of experience with formulating and manufacturing special nutritive TruPRAS™ media that never comes into contact with oxygen. We provide a wide range of media for specimen collection and transport, enriched plated agar media, and enriched liquid media specifically designed for culturing even organisms that were previously thought to be unculturable.